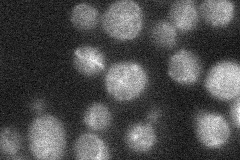
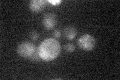

View description
Low affinity vacuolar membrane localized monovalent cation/H+ antiporter; member of the calcium exchanger (CAX) family; potential Cdc28p substrate
Localization:
Intensity:
Fold change:
Significance:
-
C’ GFP library in SD

below threshold19.49 -
N' NOP1pr-GFP in SD

vacuole membrane47.8447 -
N' TEF2pr-mCherry in SD

vacuole membrane43.0199 -
N' NATIVEpr-GFP in SD
ambiguous15.9438 -
N' TEF2pr-VC and Cyto-VN in SD

vacuole membrane39.3584 -
C’ GFP library in SD+DTT

cytosol16.480.84No -
C’ GFP library in SD+H2O2

cytosol17.140.87No -
C’ GFP library in Starvation Media
cytosol19.230.98No -
C’ GFP library on the background of Pup2-DaMP

below threshold -
C’ GFP library on the background of CCT mutant

below threshold15.82210.811565No
